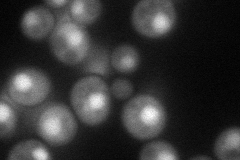
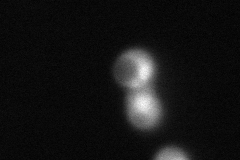
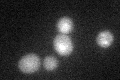

View description
Second largest subunit of DNA polymerase II (DNA polymerase epsilon), required for normal yeast chromosomal replication; expression peaks at the G1/S phase boundary; potential Cdc28p substrate
Localization:
Intensity:
Fold change:
Significance:
-
C’ GFP library in SD

below threshold17.83 -
N' NOP1pr-GFP in SD
cytosol,nucleus61.7142 -
N' TEF2pr-mCherry in SD
vacuole0 -
N' NATIVEpr-GFP in SD

nucleus28.2273 -
N' TEF2pr-VC and Cyto-VN in SD

#N/A0 -
C’ GFP library in SD+DTT
cytosol16.860.94No -
C’ GFP library in SD+H2O2

cytosol16.910.94No -
C’ GFP library in Starvation Media

cytosol15.640.87No -
C’ GFP library on the background of Pup2-DaMP

below threshold -
C’ GFP library on the background of CCT mutant

below threshold18.75271.05115No
